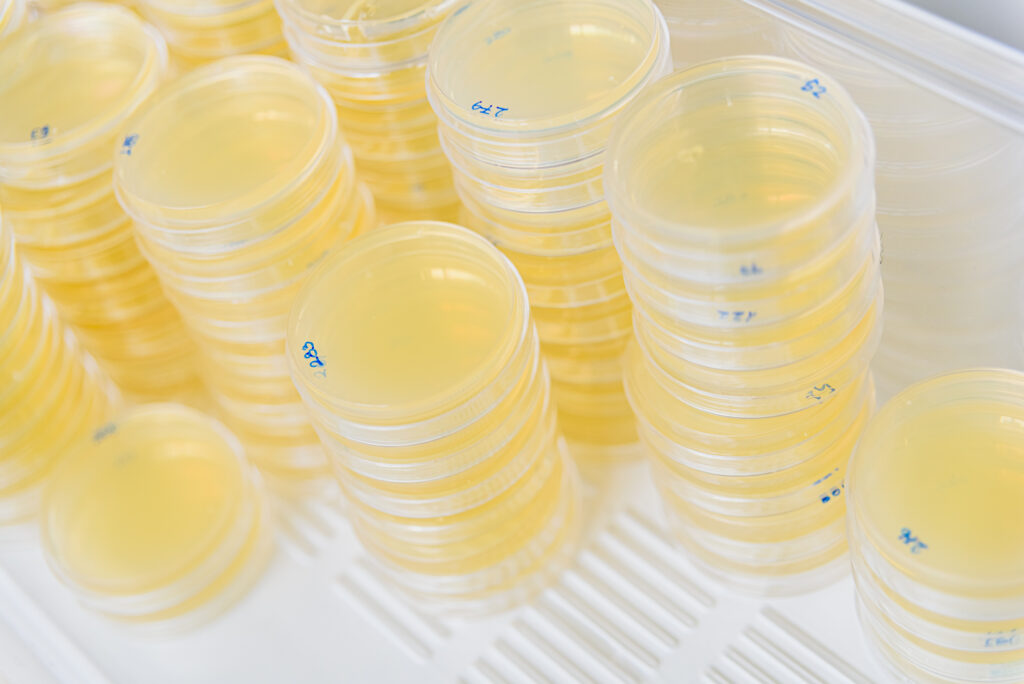
Stacks of petri dishes used in routine laboratory workflows

Introduction
Laboratory protocols are designed to describe experimental conditions with clarity and reproducibility in mind. They focus on variables that directly influence biological outcomes—such as media composition, incubation parameters, and timing—while assuming that routine consumables like Petri dishes perform consistently under standard use. As a result, the role of the dish itself is rarely examined in detail.
In a previous discussion on why Petri dish–related issues tend to remain invisible at the protocol level yet emerge during daily laboratory work, we explored how workflow assumptions and repetition gradually expose small sources of friction. Those observations highlighted why such problems are often overlooked in experimental design. What they did not fully address, however, is how these issues take shape during routine handling.
In practice, once experiments move beyond occasional use and into repeated, day-to-day workflows, Petri dishes begin to interact with handling patterns, incubation conditions, and operational constraints in more noticeable ways. The resulting issues rarely appear as single points of failure. Instead, they accumulate subtly—affecting handling efficiency, observation clarity, and result consistency over time. This article builds on that earlier, more conceptual discussion by examining the specific, practical problems that commonly arise in routine laboratory use, and where they tend to originate within everyday workflows.
Uneven Media Thickness and Surface Flatness Issues
In routine laboratory work, uneven media thickness is often one of the first issues to be noticed—though rarely identified explicitly. After pouring and solidification, some plates appear visually acceptable at a glance but reveal subtle thickness differences once colonies begin to develop or diffusion patterns are observed. These variations are usually small, yet they can become difficult to ignore when plates are handled and compared repeatedly.
From a practical standpoint, media thickness is influenced not only by pouring technique but also by the flatness and dimensional consistency of the Petri dish itself. Minor surface irregularities or slight deviations in dish geometry can affect how liquid media spreads before solidifying. In occasional experiments, such effects may go unnoticed. In routine workflows, however, they tend to recur often enough to raise questions about consistency.
For applications that rely on visual comparison—such as colony morphology assessment, density estimation, or diffusion-based assays—even small differences in media thickness can alter how results are perceived. Colonies may appear unevenly distributed, diffusion zones may look asymmetric, and repeated runs can feel harder to interpret with confidence. Importantly, these outcomes are rarely traced back to the dish; they are more commonly attributed to normal experimental variation.
Over time, the cumulative effect of these subtle inconsistencies can increase the interpretive burden on laboratory staff. Additional judgment calls are required to decide whether observed differences are biologically meaningful or simply artifacts of the setup. While such issues do not usually compromise experimental validity outright, they can affect repeatability and slow down routine decision-making—especially in workflows that depend on frequent side-by-side comparison of plates.
Condensation and Moisture Accumulation During Incubation
Condensation is another issue that becomes difficult to ignore once Petri dishes are used repeatedly in routine incubation workflows. Plates that appear clear and well prepared at the time of setup may develop visible moisture on the lid or inner surfaces after incubation begins. While this is a familiar occurrence in many laboratories, its practical implications are often underestimated.
From a workflow perspective, condensation is closely linked to temperature differentials and humidity changes during incubation. As plates move from preparation areas into incubators, or between different temperature zones, moisture in the enclosed air can condense on cooler surfaces. The extent to which this occurs is influenced not only by incubation conditions but also by the geometry of the dish and the way the lid sits during use. Small differences in surface shape or lid fit can alter where moisture accumulates and how it behaves over time.
In daily laboratory work, the presence of condensation introduces several layers of friction. Visibility through the lid may be reduced, making colony observation or documentation less straightforward. In some cases, accumulated droplets can shift position when plates are moved, creating localized disturbances on the media surface. These effects rarely invalidate an experiment outright, but they add uncertainty and require additional attention from the operator.
What makes condensation particularly challenging in routine workflows is its variability. Two plates prepared under similar conditions may behave differently during incubation, leading to inconsistent visual outcomes. As a result, condensation-related issues are often treated as incidental or unavoidable. Over repeated runs, however, they can contribute to a sense that results are harder to compare and that handling practices need constant adjustment—without a clear indication of where the underlying cause lies.
Lid Fit Consistency and Venting-Related Issues
In routine laboratory work, the fit of a Petri dish lid is often judged intuitively rather than analytically. Operators tend to notice when a lid feels unusually loose or unexpectedly tight, but such observations are rarely documented or discussed in detail. Over time, however, inconsistent lid fit becomes a recurring source of uncertainty, particularly in workflows that rely on repeated handling and incubation.
From a practical perspective, lid fit influences how the internal environment of a plate behaves during use. Small variations in how the lid sits can affect air exchange, moisture retention, and the stability of conditions inside the dish. When lid fit is consistent, these factors tend to remain predictable. When it is not, subtle differences between plates may begin to appear, even when preparation steps are otherwise identical.
In daily workflows, these inconsistencies often manifest as handling-related friction rather than obvious experimental errors. Plates may feel different to open or close, lids may shift slightly during movement, or stacking behavior may vary from one plate to another. Individually, such effects are minor. Across multiple plates and repeated runs, they can make routine tasks feel less controlled and more dependent on operator experience.
Because lid fit issues rarely produce immediate, measurable failures, they are frequently attributed to normal variation. Yet in laboratories where consistency and comparability are important, this reliance on “feel” rather than defined expectations can increase interpretive burden. When differences in growth patterns, surface appearance, or moisture behavior are observed, it becomes harder to determine whether they reflect biological variation or small, cumulative differences in how each plate behaves during incubation.
Stacking Stability and Handling Friction in Daily Workflows
As laboratory work shifts from single-plate handling to routine, multi-plate workflows, stacking behavior becomes increasingly relevant. Petri dishes are rarely used in isolation; they are moved, stored, incubated, and transported in groups. In this context, even small differences in stacking stability can influence how smoothly daily tasks are carried out.
From an operational standpoint, stacking stability is shaped by factors such as edge geometry, base flatness, and overall dimensional consistency. When plates stack evenly, handling tends to feel predictable and controlled. When they do not, minor misalignments can introduce hesitation—plates feel less secure when lifted, repositioned, or transferred between work areas. These effects are subtle, but they become more noticeable as the number of plates increases.
In routine laboratory workflows, handling friction often appears as a gradual slowdown rather than a clear problem. Extra care is taken when moving stacks, adjustments are made to avoid slippage, and attention is divided between the experimental task and the mechanics of handling. Over time, these small interruptions accumulate, particularly in environments where efficiency and throughput matter.
What makes stacking-related issues difficult to address is that they rarely register as technical faults. Protocols do not account for how plates feel in hand or how easily they align when stacked. As a result, inconsistencies are typically absorbed into the workflow rather than examined directly. When combined with other minor variations—such as lid fit or surface flatness—handling friction can reflect broader interactions between routine workflows and the general laboratory plastics used to support them, even when experimental steps themselves remain unchanged.
Warping or Deformation After Temperature Changes
In routine laboratory workflows, Petri dishes are frequently exposed to temperature changes—during incubation, storage, or transitions between work areas. While these shifts are expected parts of daily operation, their effects on dish behavior are not always immediately apparent. In some cases, plates that initially appear uniform may begin to show subtle changes in flatness or lid alignment after exposure to sustained temperature differences.
From a practical perspective, minor warping or deformation does not usually present as a dramatic visual defect. Instead, it may be sensed indirectly. Plates may no longer sit perfectly flat on the bench, lids may feel slightly misaligned, or stacking behavior may change compared to earlier handling. Because these changes are gradual and often reversible to some degree, they are easy to overlook or attribute to handling variability.
In repeated workflows, however, such deformation can interact with other small inconsistencies. A plate that no longer rests evenly may influence media distribution, condensation patterns, or stacking stability. Individually, none of these effects is decisive. Together, they can make routine tasks feel less predictable and require additional attention from the operator to maintain consistency across runs.
What complicates interpretation is that temperature-related deformation rarely follows a uniform pattern. Some plates may be more affected than others under similar conditions, leading to mixed outcomes within the same batch. As a result, these effects are often absorbed into the background of routine work rather than identified as a contributing factor. Over time, this can reinforce the impression that small variations are unavoidable, even when experimental steps are carefully controlled.
Why These Issues Accumulate in Routine Laboratory Work

Individually, the issues discussed above—uneven media thickness, condensation, lid fit variability, stacking instability, and subtle deformation—are rarely viewed as significant on their own. In many laboratories, they are treated as background noise: inconveniences that operators learn to accommodate through experience and adjustment. It is this adaptability that allows routine work to continue without frequent interruption.
The cumulative effect of these issues becomes apparent only through repetition. As plates are prepared, incubated, observed, and compared day after day, small inconsistencies begin to intersect. A slight variation in surface flatness may influence how condensation appears; changes in lid fit may alter stacking behavior; minor deformation may affect how confidently plates can be handled or compared. Over time, these interactions add complexity to workflows that are otherwise designed to be standardized.
What distinguishes routine laboratory work from one-off experiments is the reliance on comparability. Results are not evaluated in isolation but against previous runs, parallel samples, or established baselines. In this context, even subtle sources of variability can increase interpretive burden. Additional judgment is required to determine whether observed differences reflect biological phenomena or operational artifacts, slowing decision-making and reducing confidence in repeated comparisons.
Because protocols typically emphasize experimental variables rather than consumable behavior, these accumulating effects are seldom traced back to the Petri dish itself. Instead, they are absorbed into technique, environment, or workflow adjustments. As discussed in our earlier article on why Petri dish–related issues often remain invisible at the protocol level but emerge during daily laboratory work, these effects tend to become noticeable only through repetition rather than isolated experimental steps. Only when such issues become persistent—requiring ongoing attention rather than occasional correction—does the underlying role of the dish begin to stand out. At that point, what was once considered a neutral tool becomes part of the experimental context, warranting closer consideration in routine laboratory practice.
Conclusion
The issues that arise during routine use of Petri dishes are rarely dramatic or immediately disruptive. Uneven media thickness, condensation, lid fit variability, stacking instability, and subtle deformation are often manageable in isolation. Most laboratories adapt to them through experience, technique adjustments, or workflow habits, allowing daily work to proceed without obvious failure.
What distinguishes these issues in routine laboratory settings is not their severity, but their persistence. When the same minor inconsistencies appear repeatedly across batches and over time, they begin to influence efficiency, comparability, and confidence in results. At this stage, the cumulative effort required to interpret outcomes, compensate during handling, or explain variation can outweigh the apparent simplicity of the consumable itself.
Recognizing this shift is important. When Petri dish–related issues move from occasional inconveniences to recurring workflow friction, the dish can no longer be treated as a fully neutral tool. Instead, its characteristics become part of the experimental context—interacting with handling practices, incubation conditions, and repetition in ways that shape daily laboratory work.
Understanding where these problems originate does not immediately dictate a solution, but it clarifies when closer attention is warranted. In routine laboratory workflows, recognizing consistent patterns in these recurring issues often marks the point at which material-related differences in Petri dishes deserve more deliberate consideration.
FAQ
Do Petri dish problems usually affect experimental results?
In most cases, Petri dish–related issues do not lead to immediate experimental failure. Routine laboratory work is often resilient enough to accommodate small inconsistencies through operator experience and workflow adjustments. However, when such issues recur over time, they can influence how results are interpreted and compared rather than whether an experiment “works” or not.
Uneven media thickness, condensation, or subtle handling differences may increase variability between plates, making it harder to assess whether observed differences are biologically meaningful. The impact is therefore more closely related to repeatability, consistency, and confidence in comparisons than to outright experimental validity.
Why are these issues rarely mentioned in laboratory protocols?
Laboratory protocols are designed to control experimental variables that directly affect biological outcomes, such as media composition, incubation conditions, and timing. They typically assume that routine consumables behave consistently under standard use and therefore do not address variations in handling or material behavior.
As a result, Petri dish–related issues often emerge only during repeated, day-to-day workflows rather than during protocol development. Because these effects accumulate gradually and are not tied to a single procedural step, they tend to remain outside formal documentation.
Are these problems more common with plastic or glass Petri dishes?
Both plastic and glass Petri dishes can exhibit workflow-related issues, but the nature of those issues may differ depending on material properties and usage patterns. Plastic dishes are commonly used for convenience and disposability, while glass dishes are typically selected for reuse and repeated sterilization.
Rather than attributing problems to one material category alone, it is often more useful to consider how dish characteristics interact with specific workflows. Factors such as consistency across batches, handling frequency, and incubation conditions tend to play a larger role than material type in isolation.
When should a laboratory consider reviewing its Petri dish specifications or suppliers?
Reviewing Petri dish specifications becomes relevant when issues shift from occasional inconveniences to recurring workflow friction. Signs may include repeated difficulty in comparing plates, increased reliance on operator judgment to explain variation, or a growing sense that routine tasks require disproportionate attention.
At this stage, the question is less about correcting individual techniques and more about whether the consumable itself has become a variable in daily work. Recognizing this transition is often the first step toward more deliberate consideration of Petri dish selection in routine laboratory workflows.
Can these issues be resolved solely through improved handling techniques?
Improved technique can reduce the visibility of certain issues, particularly in low-frequency or short-term experiments. However, in routine workflows that involve repeated handling and comparison, technique alone may not fully address recurring inconsistencies.
When workflow adjustments no longer provide sufficient control, it may indicate that underlying dish characteristics are contributing to the observed variability. In such cases, evaluating whether current Petri dish specifications align with routine use requirements can be a more effective approach than continued procedural fine-tuning.
If you are evaluating Petri dish materials for standardization or procurement, and need input aligned with your specific workflow
📩 For quotes, samples, or product recommendations, contact the Kelabscience team → Contact Kelabscience


